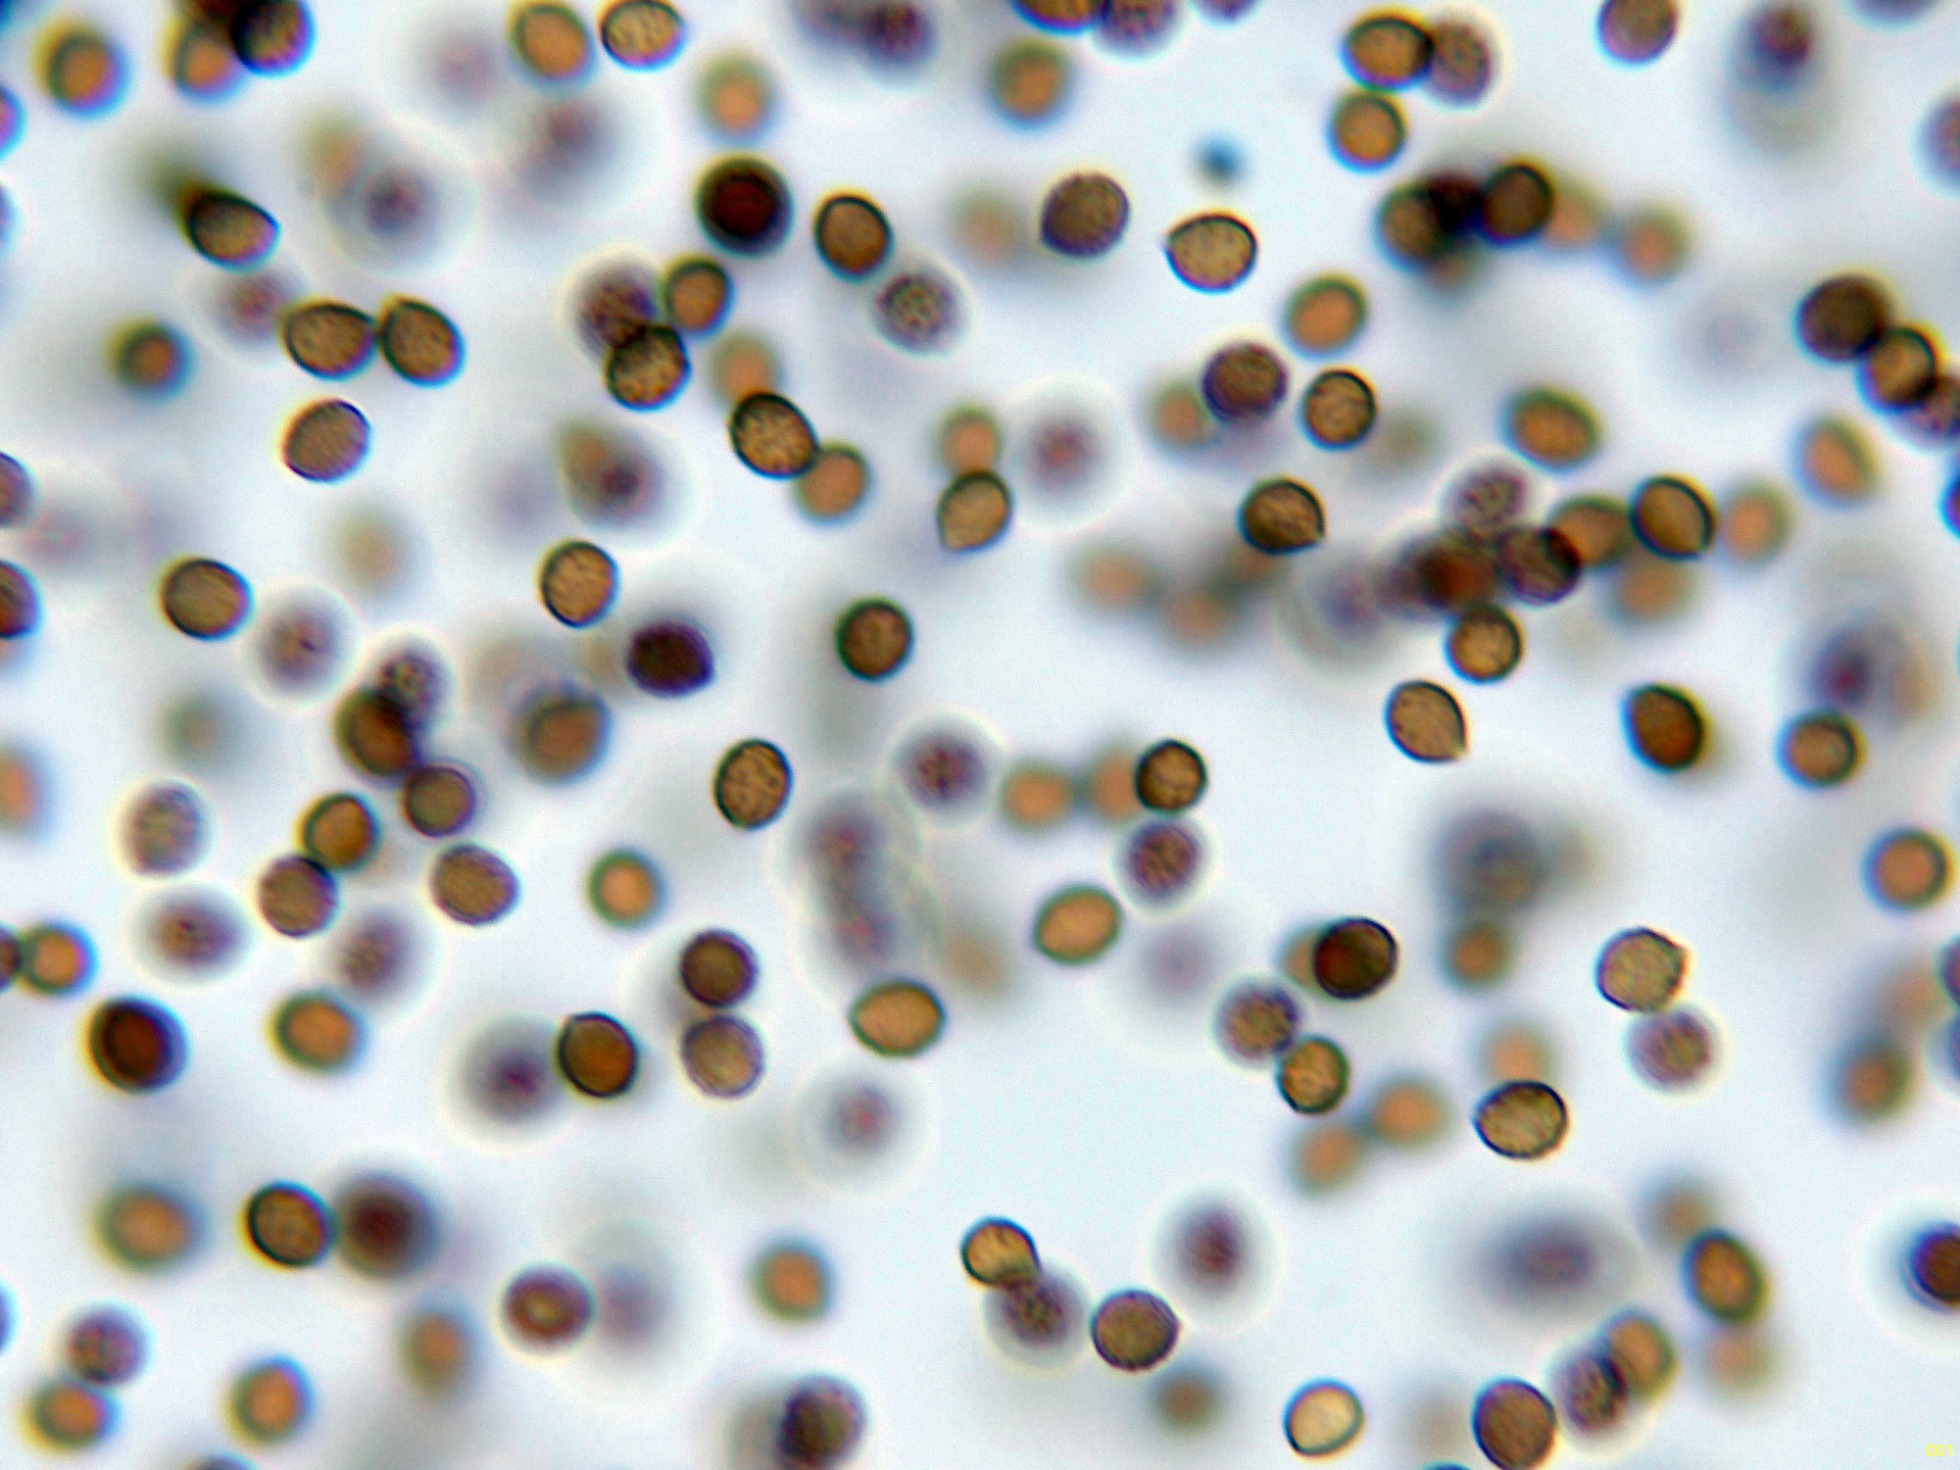

- Foro
- Foros sobre Micología de fungipedia
- Microscopía
- Fungimasters 2024: (13) Cortinarius venetus (Fr.) Fr.
 Fungimasters 2024: (13) Cortinarius venetus (Fr.) Fr.
Fungimasters 2024: (13) Cortinarius venetus (Fr.) Fr.
- Josep Torres
-
 Autor del tema
Autor del tema
- Ausente
- Moderador
-

Menos
Más
- Mensajes: 8746
- Gracias recibidas: 8379
1 año 4 meses antes - 1 año 4 meses antes #110339
por Josep Torres
Hola.
El último de los Cortinarius recolectados con los Fungimasters del pasado 1 de noviembre, el:
Cortinarius venetus (Fr.) Fr.
Las hifas de la suprapellis en agua, con hifas terminales con formas redondeadas:
Las hifas tramales:
Arista laminar sin elementos claramente diferenciados de los basidios o basidiolos:
Los basidios de la cara laminar:
Detalle de un basidio tetraspórico (con 4 esterigmas).
Las pequeñas esporas en reactivo de Melzer, con reacción dextrinoide:
Y por último las esporas enn agua:
Estas esporas obtenidas por esporulación natural y en agua con unas medidas de:
(5.9) 6.1 - 6.8 (7.3) × (4.6) 5 - 5.9 (6.2) µm
Q = (1.1) 1.12 - 1.27 (1.3) ; N = 40
Me = 6.4 × 5.4 µm ; Qe = 1.2
Saludos.
El último de los Cortinarius recolectados con los Fungimasters del pasado 1 de noviembre, el:
Cortinarius venetus (Fr.) Fr.
Las hifas de la suprapellis en agua, con hifas terminales con formas redondeadas:
Las hifas tramales:
Arista laminar sin elementos claramente diferenciados de los basidios o basidiolos:
Los basidios de la cara laminar:
Detalle de un basidio tetraspórico (con 4 esterigmas).
Las pequeñas esporas en reactivo de Melzer, con reacción dextrinoide:
Y por último las esporas enn agua:
Estas esporas obtenidas por esporulación natural y en agua con unas medidas de:
(5.9) 6.1 - 6.8 (7.3) × (4.6) 5 - 5.9 (6.2) µm
Q = (1.1) 1.12 - 1.27 (1.3) ; N = 40
Me = 6.4 × 5.4 µm ; Qe = 1.2
Saludos.
Adjuntos:
Última Edición: 1 año 4 meses antes por Josep Torres. Razón: Una falta de ortografía
El siguiente usuario dijo gracias: Juan Andrés Román
Por favor, Identificarse para unirse a la conversación.
- Foro
- Foros sobre Micología de fungipedia
- Microscopía
- Fungimasters 2024: (13) Cortinarius venetus (Fr.) Fr.
Tiempo de carga de la página: 0.176 segundos

Foro de micología